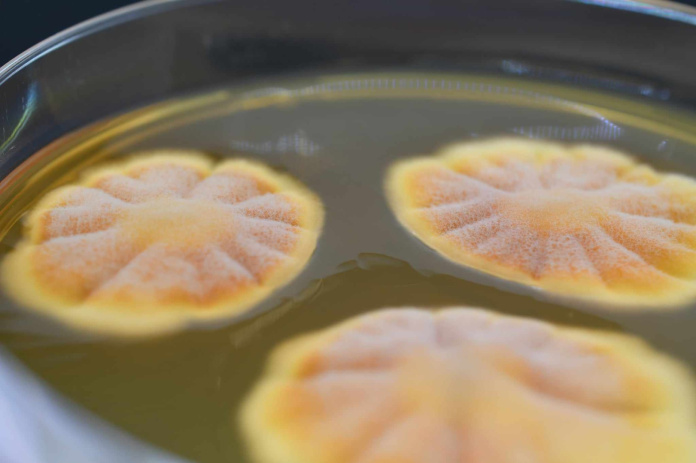

-
SZKOLENIE "Podstawy mykologii medycznej."
















PODSTAWY MYKOLOGII MEDYCZNEJ. KURS DLA DIAGNOSTÓW LABORATORYJNYCH.
| Cena przesyłki | 0 |
| Dostępność |
Mało
|
| Waga | 0.15 kg |
| Kod kreskowy | |
| EAN |
Zamówienie telefoniczne: 605262226
| Zostaw telefon |
Serdecznie zapraszamy na kolejny kurs z udziałem dr n.med. Pawłem Krzyściakiem.
Podstawy mykologii medycznej.
Planowany kurs ma na celu upowszechnianie aktualnej wiedzy z zakresu mykologii medycznej, szczególnie w kontekście prawidłowego postępowania z materiałem klinicznym oraz rozpoznawania sytuacji wymagających diagnostyki mikrobiologicznej.
Szkolenie adresowane jest do diagnostów laboratoryjnych oraz specjalistów zajmujących się profesjonalną pielęgnacją stóp – w szczególności w celu poprawy jakości współpracy z laboratoriami i właściwego kierowania pacjentów.
Merytoryczny charakter kursu oraz jego zgodność z aktualnymi standardami diagnostycznymi ma na celu upowszechnianie aktualnej wiedzy z zakresu mykologii medycznej, ze szczególnym uwzględnieniem praktycznych aspektów diagnostyki i współpracy interdyscyplinarnej.
Szkolenie służy poprawie jakości pobierania i przesyłania materiałów do badań, podnosząc świadomość znaczenia diagnostyki mikrobiologicznej oraz promowanie współpracy między laboratorium a praktyką kliniczną i pielęgnacyjną.
Tematyka wydarzenia jest w pełni zgodna z celami statutowymi Polskiego Towarzystwa Mykologicznego – w zakresie promowania wiedzy mykologicznej, wspierania edukacji zawodowej oraz popularyzacji standardów diagnostycznych.
Spotkanie ma charakter seminaryjno-warsztatowy z ograniczoną liczbą miejsc. Czas realizacji 9-16.
ZAGADNIENIA PROGRAMOWE:
1. Wprowadzenie do mykologii medycznej – Umiejscowienie grzybów w taksonomii – grupy patogenów człowieka – Podstawowe terminy – Przegląd epidemiologii zakażeń grzybiczych2. Grzyby chorobotwórcze człowieka – znaczenie kliniczne i diagnostyczne – Dermatofity – Drożdże – Pleśnie (w tym sprzężniaki) – Grzyby dimorficzne3. Diagnostyka zakażeń grzybiczych – Prawidłowe pobieranie i transport materiału – Rola preparatu bezpośredniego – Diagnostyki zintegrowana z obrazem klinicznym4. Hodowla i identyfikacja – Podłoża, warunki hodowli, typowe cechy kolonii – Identyfikacja fenotypowa i jej ograniczenia – Nowoczesne narzędzia: MALDI-TOF, testy komercyjne5. Biologia molekularna w diagnostyce zakażeń grzybiczych – Spektroskopia mas (MALDI-TOF)bezpośredniej – Rola PCR w diagnostyce grzybic6. Oznaczanie lekowrażliwości grzybów (AFST) – Najczęstsze metody w odniesieniu do metod odniesienia (EUCAST, CLSI) – Mechanizmy oporności – Znaczenie AFST w terapii i monitorowaniu skuteczności leczenia7. Znaczenie kliniczne zakażeń grzybiczych – przypadki i omówienie – Zakażenia inwazyjne oportunistyczne: Candida, Aspergillus, Cryptococcus – Zakażenia błon śluzowych: drożdże – diagnostyka i różnicowanie – Zakażenia skóry i przydatków: dermatofity i grzyby drożdżopodobne
Cena szkolenia obejmuje: materiały szkoleniowe, certyfikat oraz serwis kawowy.
Organizator: Servitium-Medyczna Strefa Zakupy i Wydarzenia

Partner:

Kilka słów o prowadzącym spotkanie:
dr n.med. Paweł Krzyściak , absolwent Uniwersytetu Jagiellońskiego Collegium Medicum w Krakowie, wieloletni pracownik Katedry Mikrobiologii (obecnie w Zakładzie Kontroli Zakażeń i Mykologii) na tej samej uczelni. Nauczyciel akademicki z 15 letnim stażem dydaktycznym. Diagnosta laboratoryjny i specjalista w dziedzinie mikrobiologii medycznej, swoją wiedzę w dziedzinie mykologii medycznej pogłębił podczas ukończonego kursu mykologii medycznej w Instytucie Pasteura w Paryżu. Jest autorem i współautorem licznych prac naukowych i doniesień zjazdowych, a także rozdziałów w podręcznikach akademickich. Jednym z jego osiągnięć jest autorstwo "Atlasu grzybów chorobotwórczych człowieka". Pozycja ta stanowi cenne źródło informacji dla specjalistów zajmujących się diagnostyką zakażeń grzybiczych u ludzi.
- Producenci
![[{[item.product.name]}]]([{[item.product.photo.url]}] 125w)









